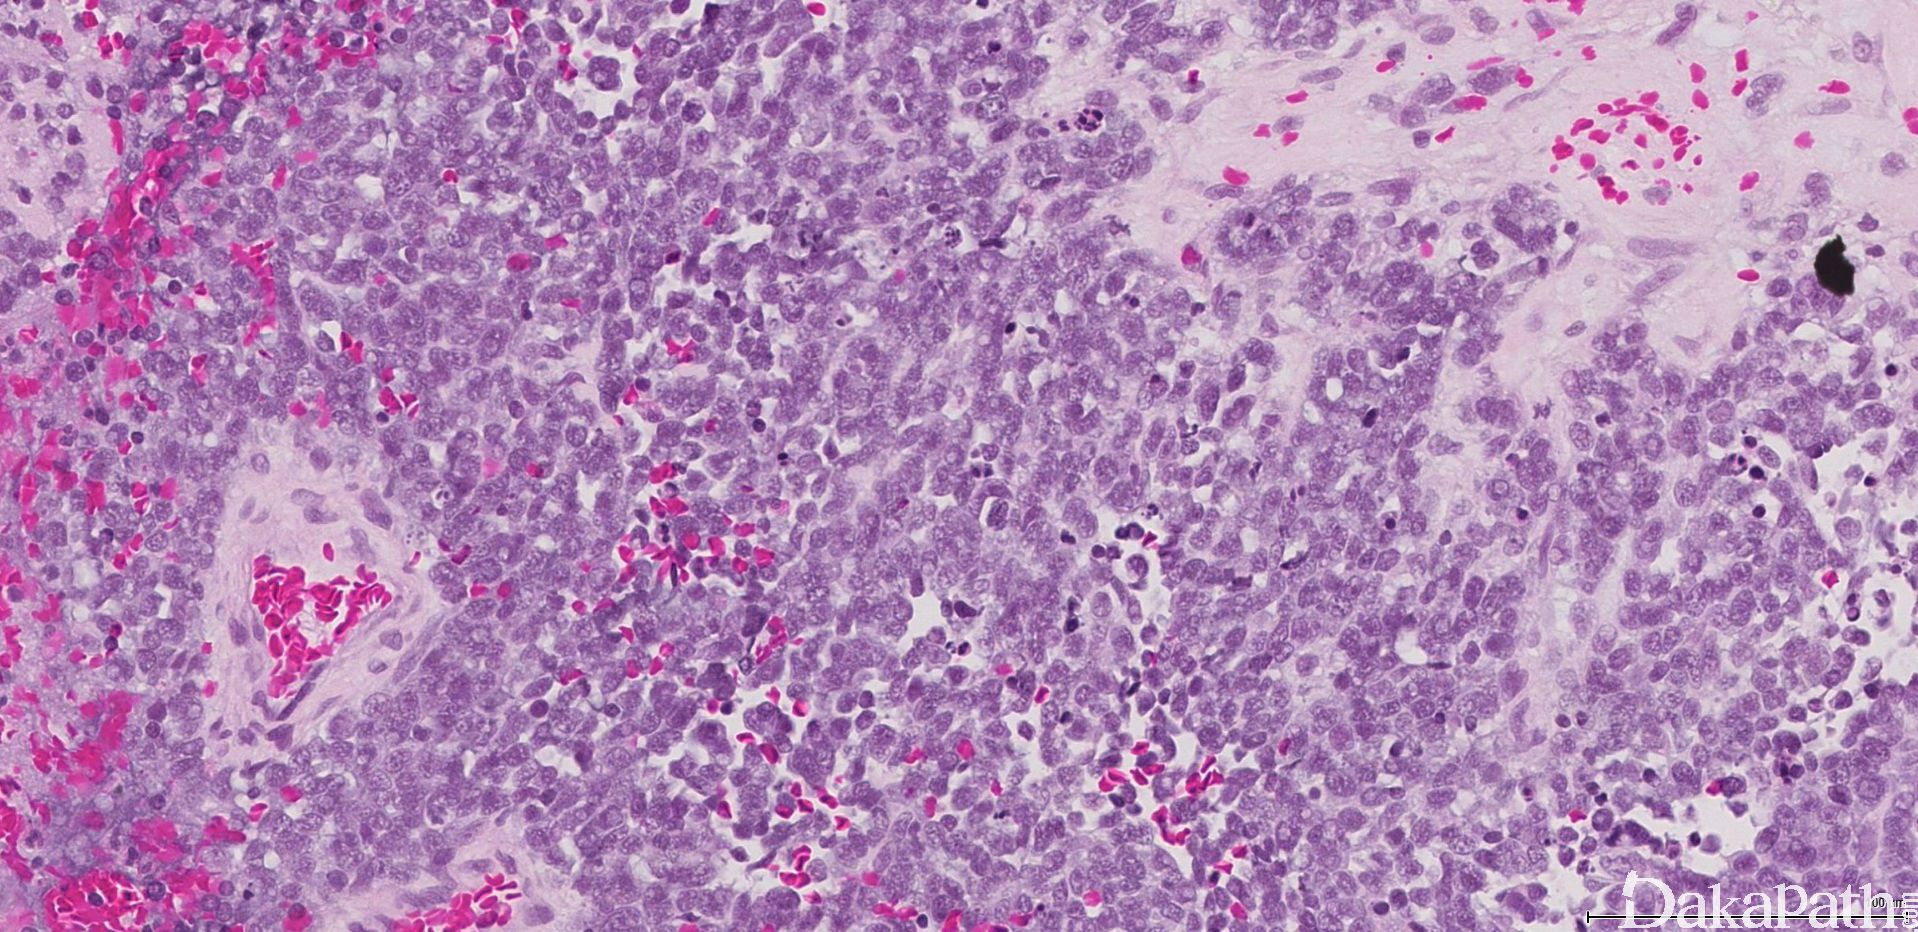
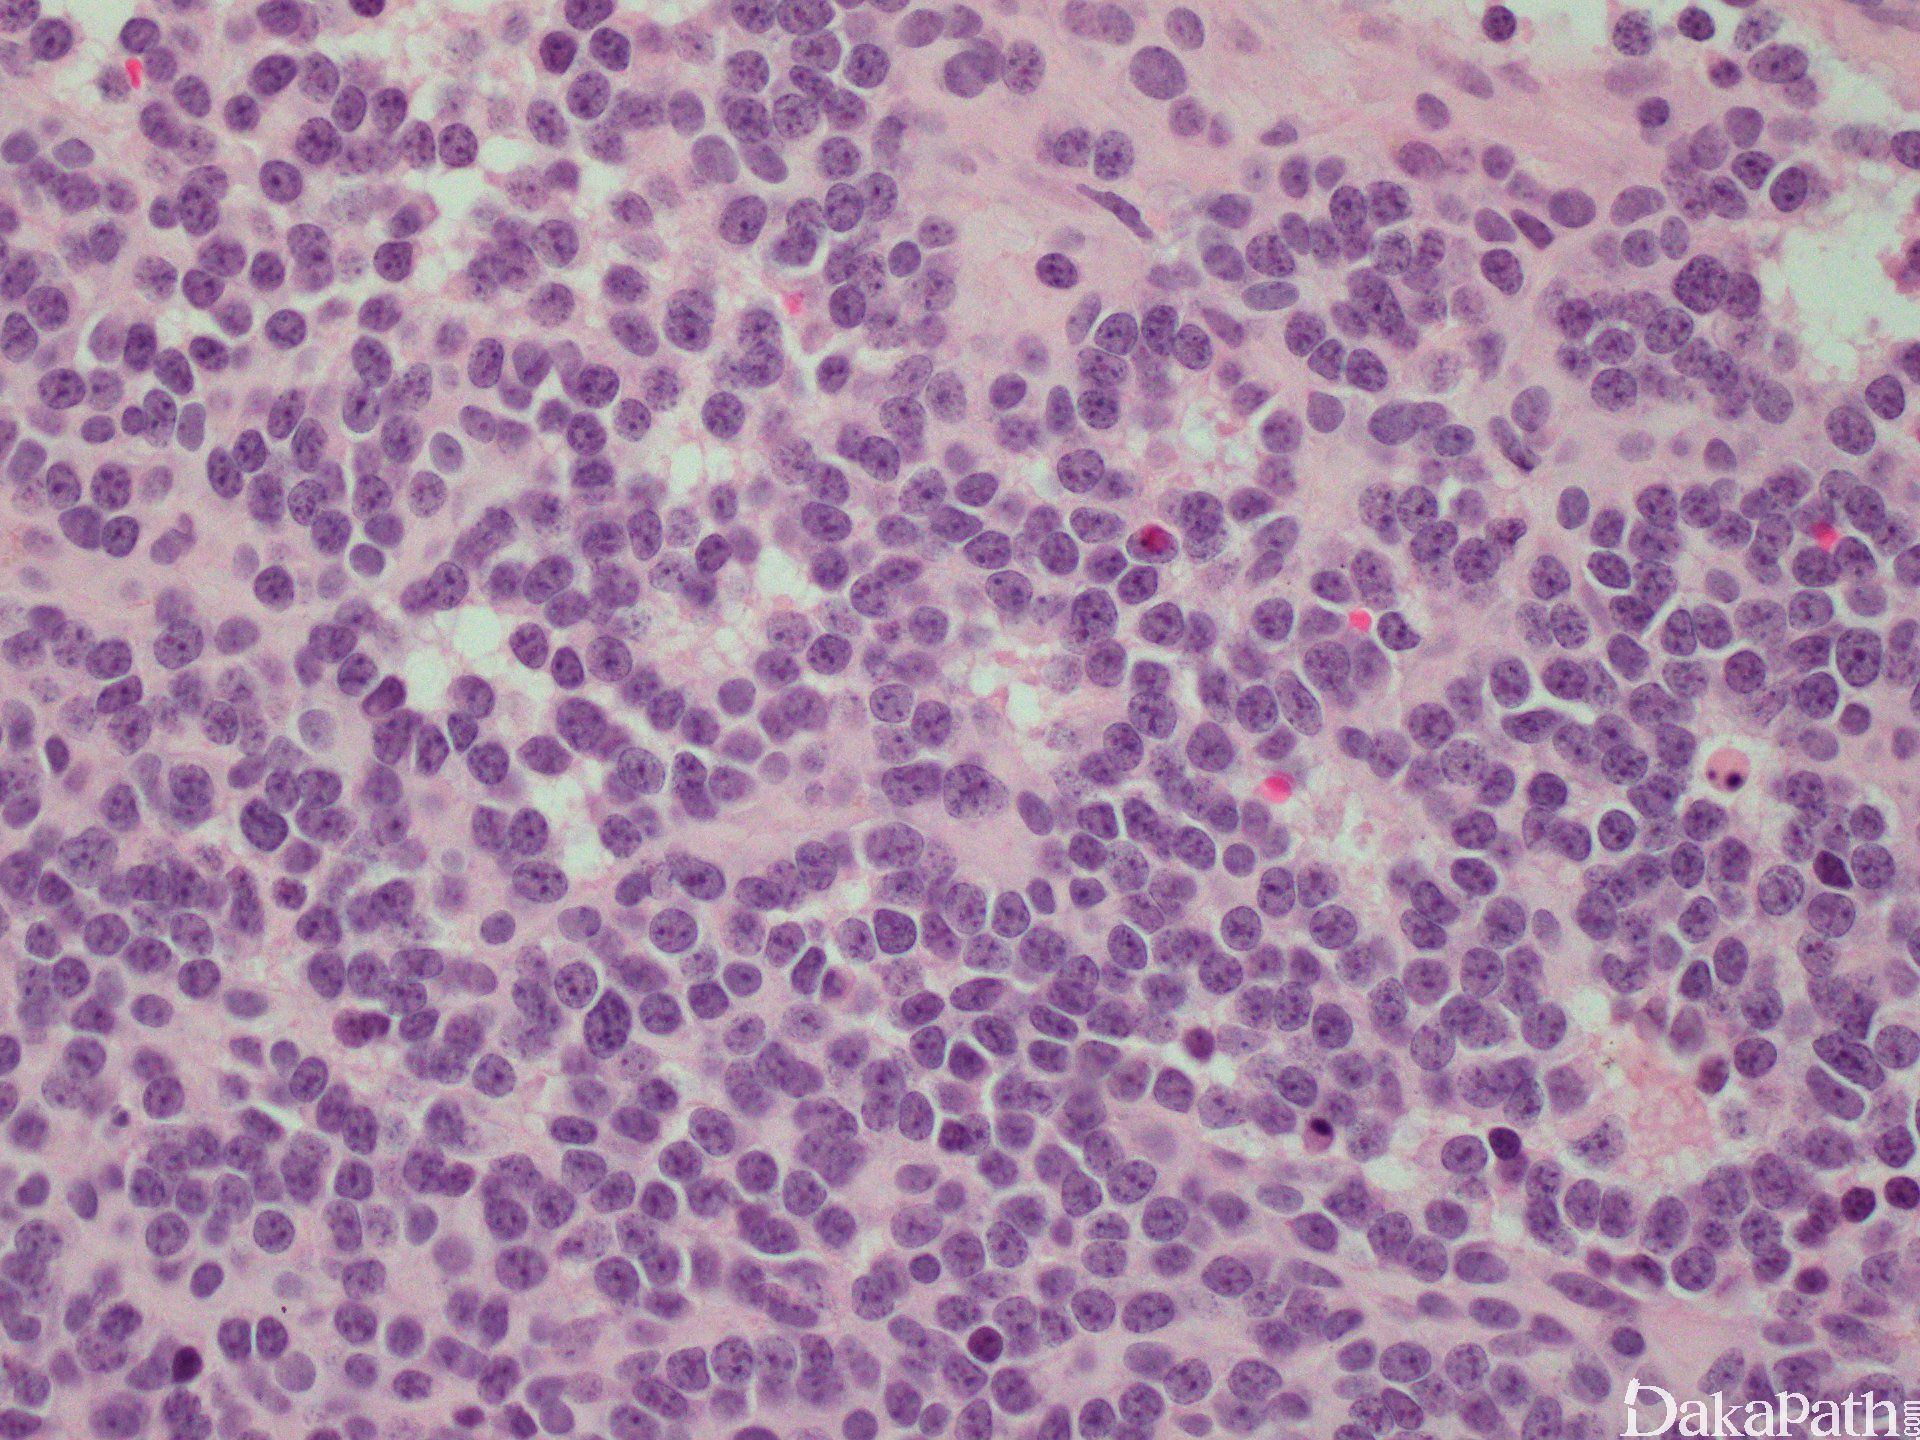

鼻窦嗅神经母细胞瘤
Olfactory Neuroblastoma(ONB)of Sinonasal Tract
概述:
起源于上鼻腔的特殊感觉神经上皮嗅细胞的恶性肿瘤,主要位于筛窦的筛状板。
发病部位: 几乎总是发生在筛窦的筛状板,少部分发生在上鼻甲、鼻中隔的上部分及鼻顶部。
诊断要点:
发病占所有鼻窦肿瘤的 2-3%,。发病年龄范围广泛,20 及 60 岁为两个发病高峰。临床表现为单侧鼻塞、鼻出血,其他症状包括头疼、疼痛、过度流泪、鼻溢液及视觉障碍,不到 5%的患者累及嗅上皮导致嗅觉功能障碍,偶见副肿瘤综合征。
大体上有光泽,有黏膜被覆,软的、息肉样肿物。切面呈灰红、灰褐色至紫色。肿瘤大小不等,可充满鼻腔及颅内,可延伸至邻近的副鼻窦及鼻咽。
组织学改变基于分化成程度不同而呈不同,原始神经母细胞分叶状排列(不管分级如何)。叶状结构之间富于纤维血管间隔,支持细胞常位于细胞巢周边。
肿瘤细胞呈经典小圆蓝细胞,比成熟淋巴细胞稍微大一些,核浆比高,小而一致的胞核伴细致、椒盐样染色质分布,胞核比较小或缺席。细胞呈合胞体样。可见中央为神经丝状物构成的菊形团(Homer Wright)。
根据分化的程度、神经间质的多少、核分裂像及坏死将肿瘤分成 4 级(Hyams Grading)。1 级:叶状分布,细胞合胞体样,可见神经丝样基质,染色质空泡状,无核分裂及核仁。2 级:神经丝基质变少,核分裂散在。3 级:细胞多形性,真菊形团可见,出现坏死。4 级:显著异型性、核分裂像及坏死。
根据核多形性、核分裂及坏死的有无将肿瘤分为低级别病变(1 级或 2 级)及高级别病变(3 级或 4 级)。核多形性、核分裂及坏死在低级别一般缺如,而在高级别中出现。
可见两种菊形团形式:假菊形团 (Homer Wright)及真菊形团(Flexner-Wintersteiner)。假菊形团见于 30%的病例,肿瘤细胞栅栏状、套样围绕在神经丝样、水肿样神经基质的周围,可见于 1 级或 2 级。真菊形团见于 5%的病例,中空导管样伴非纤毛样柱状细胞,可见与 3 级或 4 级。围血管性菊形团没有诊断价值。
可见砂砾体样或凝结物样钙化,随着级别的增高,出现的频率降低。偶见血管浸润、神经节细胞或节细胞神经母细胞分化、含有黑色素细胞及横纹肌母细胞样细胞。
表面上皮完整。

免疫组织化学染色:
肿瘤细胞神经内分泌标记、calretinin 阳性;支持细胞 S100. GFAP 阳性。低分子量角蛋白(CAM5.2)偶尔阳性;而 Desmin、 myogenin、CD45RB 及 CD99 阴性。
鉴别诊断:
鼻窦未分化癌 (SNUC) 高级别,具有广泛破坏性,大量凝固性坏死及血管浸润,弥漫角蛋白强阳性,可显示少量神经内分泌标记。
神经内分泌癌 (Neuroendocrine Carcinoma) 伴有大量坏死、核分裂像高及凋亡的高级别肿瘤,角蛋白核周点状阳性,TTF1 常阳性。
鼻型结外 NK/T 细胞淋巴瘤 (Extranodal NK-/T-Cell Lymphoma, Nasal Type) 伴有广泛血管浸润及凝固性坏死的高级别肿瘤,NK、T 细胞标记呈阳性,而神经内分泌标记、S100 及角蛋白阴性。
NUT 中线癌 (NUT Midline Carcinoma) 伴突然角化的分化差的高级别癌,常位于年轻的患者,大部分位于中线,伴 t(15;19) (q14;p13)。利用 FISH 或 RT-PCR 技术检测染色体 15q14 上 NUT 基因检测,BRD4 (19p13.1) 与 NUT (15q14)的平衡易位产生融合基因 BRD4-NUT。常常表达 CD34。
横纹肌肉瘤 (Rhabdomyosarcoma) 横纹肌细胞伴有偏心嗜酸性胞浆,肌源性标记阳性,角蛋白、CD56 在 5-10%的病例中呈阳性。
恶性黑色素瘤 (Malignant Melanoma) 含有多种细胞形态及多种结构,多边形细胞,嗜酸性浆样胞浆,核内浆样包涵体及色素。S100 protein, HMB-45, Melan-A, SOX10 阳性,而神经内分泌标记阴性。
尤文肉瘤** **/PNET(PNET/Ewing Sarcoma) 小蓝圆细胞肿瘤显示凝固性坏死,弥漫片状细胞伴有模糊细胞边界,一致小细胞伴细致分散的染色质及小核仁。FLI-1, CD99, NSE 阳性; synaptophysin 时而阳性;而 Chromogranin, GFAP 呈阴性。FISH 检测可见 t(11;22)(q24;q12)。
垂体腺瘤 (Pituitary Adenoma) 蝶窦肿物,缎带样、丝带样、叶状结构,多边形细胞,缺乏多形性及核分裂像。神经内分泌及神经肽、角蛋白呈阳性。
髓外浆细胞瘤 (Extramedullary Plasmacytoma) 浆样细胞含有仪表盘样核染色质分布,核周空晕。CD138, CD79a, κ 或 λ 限制性表达呈阳性。上皮及神经内分泌标记呈阴性。
转移性神经母细胞瘤 (Metastatic Neuroblastoma) 组织学与该种瘤相似,但具有 MYC 扩增。
